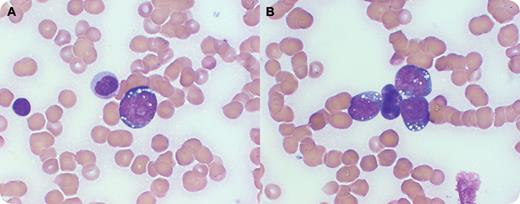
A 47-year-old male with headaches for 2 months developed slurred speech. Physical examination showed a large, 7-cm left neck mass and splenomegaly. Complete blood count revealed leukocytosis (33.3 × 109/L), normocytic anemia (11.5 g/dL), and thrombocytopenia (20 × 109/L). The peripheral smear (panels A and B) revealed markedly decreased platelets, mild anisocytosis, multiple blasts (38%), some with vacuoles, and prominent nucleoli and occasional folded nuclei. The bone marrow biopsy showed diffuse infiltration by medium-sized blasts with high Ki-67/MIB, compatible with Burkitt lymphoma (BL). A diagnosis of leukemic phase of BL was made. / The neurologic symptoms prompted brain imaging that was negative. However, a lumbar puncture showed the presence of lymphoid cells with the same characteristics as the malignant lymphoma. Finally, HIV testing was positive. The patient was started on intrathecal methotrexate and high-dose intravenous chemotherapy, but died shortly afterward from septicemia. / Adult Burkitt lymphoma and Burkitt cell leukemia are rare, aggressive B-cell malignancies currently recognized by the proposed World Health Organization classification of lymphoid neoplasms as a single entity. Improved outcomes have been noted with modern combination chemotherapy. BL can be endemic (African), sporadic, or associated with AIDS. AIDS-related BL carries the worst prognosis. This patient also had leptomeningeal lymphoma.

A 47-year-old male with headaches for 2 months developed slurred speech. Physical examination showed a large, 7-cm left neck mass and splenomegaly. Complete blood count revealed leukocytosis (33.3 × 109/L), normocytic anemia (11.5 g/dL), and thrombocytopenia (20 × 109/L). The peripheral smear (panels A and B) revealed markedly decreased platelets, mild anisocytosis, multiple blasts (38%), some with vacuoles, and prominent nucleoli and occasional folded nuclei. The bone marrow biopsy showed diffuse infiltration by medium-sized blasts with high Ki-67/MIB, compatible with Burkitt lymphoma (BL). A diagnosis of leukemic phase of BL was made.
The neurologic symptoms prompted brain imaging that was negative. However, a lumbar puncture showed the presence of lymphoid cells with the same characteristics as the malignant lymphoma. Finally, HIV testing was positive. The patient was started on intrathecal methotrexate and high-dose intravenous chemotherapy, but died shortly afterward from septicemia.
Adult Burkitt lymphoma and Burkitt cell leukemia are rare, aggressive B-cell malignancies currently recognized by the proposed World Health Organization classification of lymphoid neoplasms as a single entity. Improved outcomes have been noted with modern combination chemotherapy. BL can be endemic (African), sporadic, or associated with AIDS. AIDS-related BL carries the worst prognosis. This patient also had leptomeningeal lymphoma.
A 47-year-old male with headaches for 2 months developed slurred speech. Physical examination showed a large, 7-cm left neck mass and splenomegaly. Complete blood count revealed leukocytosis (33.3 × 109/L), normocytic anemia (11.5 g/dL), and thrombocytopenia (20 × 109/L). The peripheral smear (panels A and B) revealed markedly decreased platelets, mild anisocytosis, multiple blasts (38%), some with vacuoles, and prominent nucleoli and occasional folded nuclei. The bone marrow biopsy showed diffuse infiltration by medium-sized blasts with high Ki-67/MIB, compatible with Burkitt lymphoma (BL). A diagnosis of leukemic phase of BL was made.
The neurologic symptoms prompted brain imaging that was negative. However, a lumbar puncture showed the presence of lymphoid cells with the same characteristics as the malignant lymphoma. Finally, HIV testing was positive. The patient was started on intrathecal methotrexate and high-dose intravenous chemotherapy, but died shortly afterward from septicemia.
Adult Burkitt lymphoma and Burkitt cell leukemia are rare, aggressive B-cell malignancies currently recognized by the proposed World Health Organization classification of lymphoid neoplasms as a single entity. Improved outcomes have been noted with modern combination chemotherapy. BL can be endemic (African), sporadic, or associated with AIDS. AIDS-related BL carries the worst prognosis. This patient also had leptomeningeal lymphoma.
For additional images, visit the ASH IMAGE BANK, a reference and teaching tool that is continually updated with new atlas and case study images. For more information visit http://imagebank.hematology.org.

This feature is available to Subscribers Only
Sign In or Create an Account Close Modal